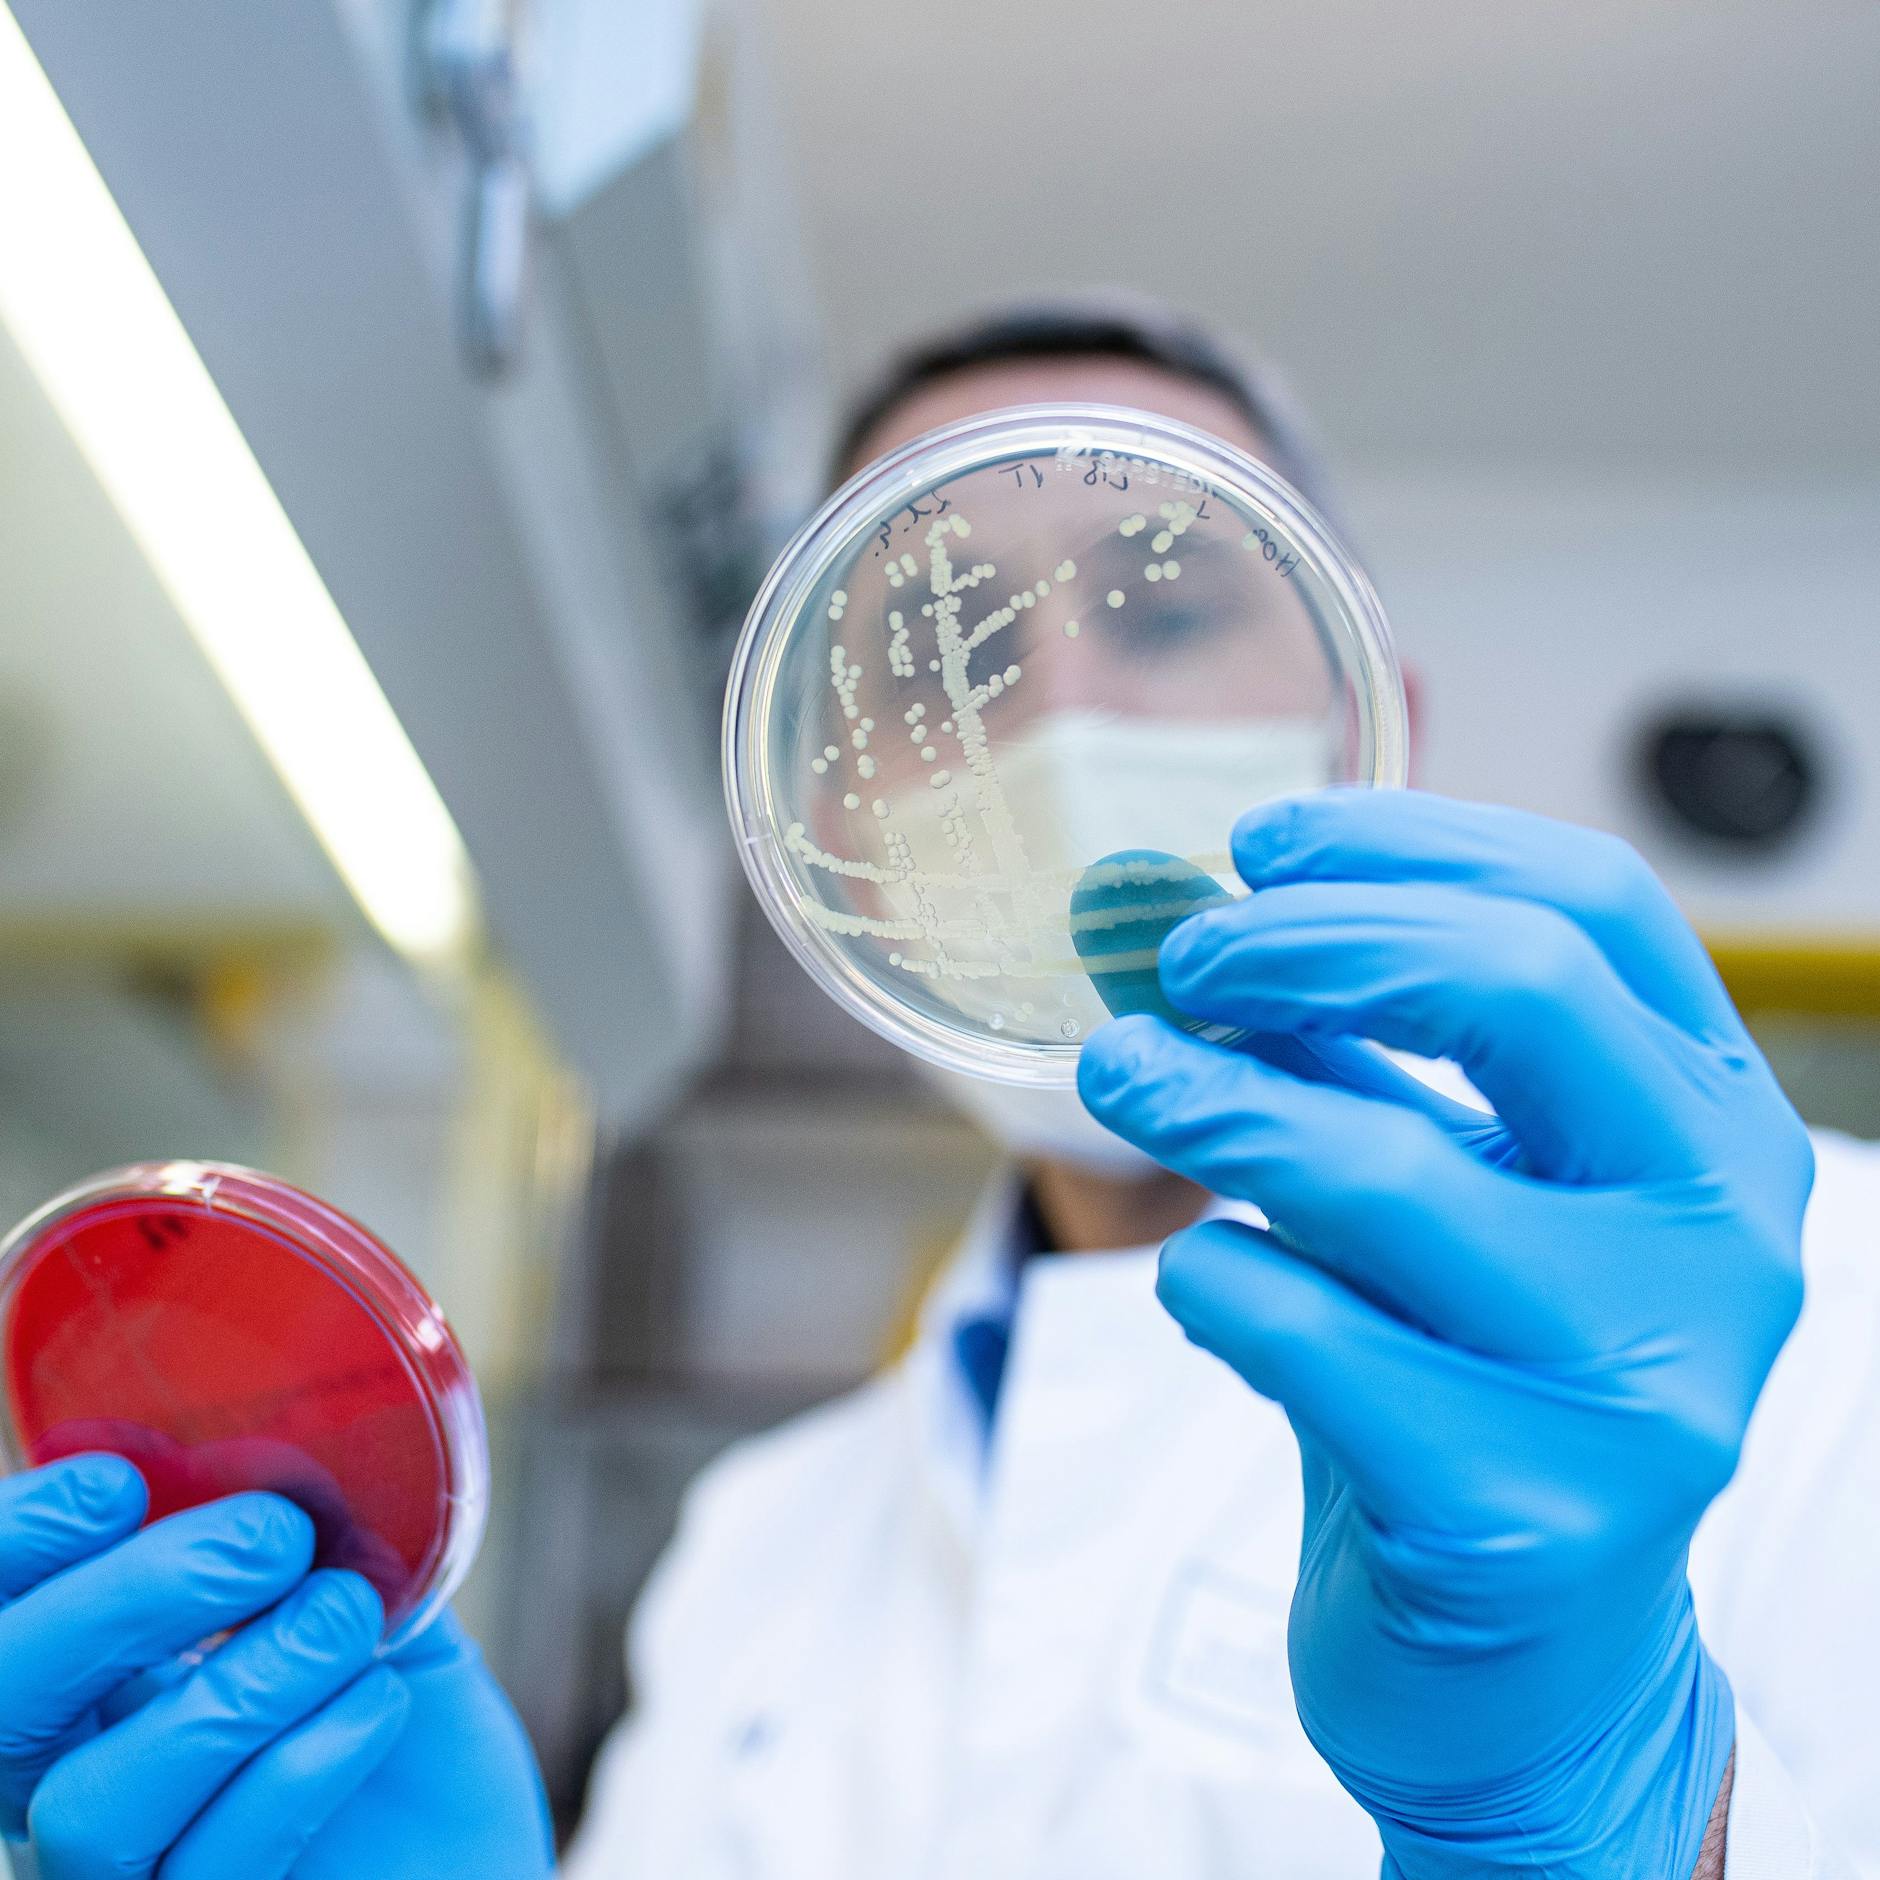
Image - Immer mehr Fälle, Wurst-Rückruf: Droht dem Osten großer Ehec-Ausbruch?

Ostdeutschland
Ostdeutschland - mit dem Begriff meint man meist die fünf ostdeutschen Bundesländer: Brandenburg, Mecklenburg-Vorpommern, Thüringen, Sachsen und Sachsen-Anhalt. Obwohl Berlin auch zu Ostdeutschland gehört, spielt es eine Sonderrolle als Hauptstadt. Jahrzehnte nach Wiedervereinigung scheint die Mauer zwischen Ost und West nicht völlig verschwunden zu sein. Millionen Menschen, die nach der Wende aus ostdeutschen Orten abwanderten, Ostdeutsche, die vielerorts im Niedriglohn-Sektor arbeiten, besonders stark unter Inflation und zeitweise gestiegenen Energiekosten leiden. Ängste und Vorbehalte gegenüber Fremden, und ältere Menschen, die der DDR hinterhertrauern: Ostdeutschland ist viel mehr, aber in den Nachrichten geht es oft um die rechtsextreme AfD und das BSW vor den Landtagswahlen in Thüringen, Sachsen und Brandenburg. Alle aktuellen News zum Thema Ostdeutschland.